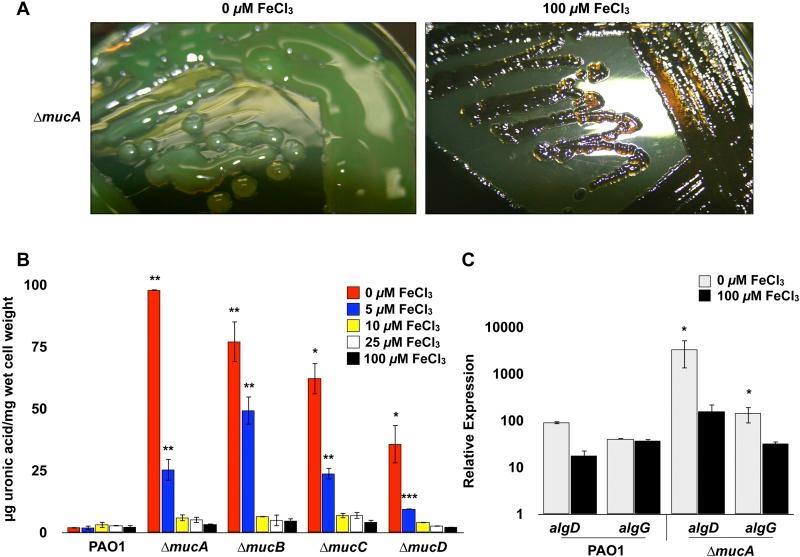
https://cdn.ncbi.nlm.nih.gov/pmc/blobs/d92f/3950519/f2059622aa8b/mbo0011417270001.jpg
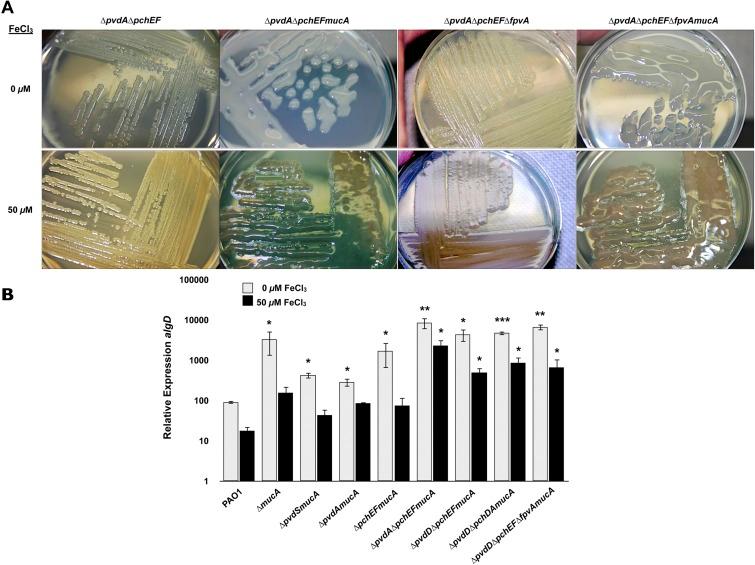
https://cdn.ncbi.nlm.nih.gov/pmc/blobs/d92f/3950519/47dce3b0761c/mbo0011417270005.jpg
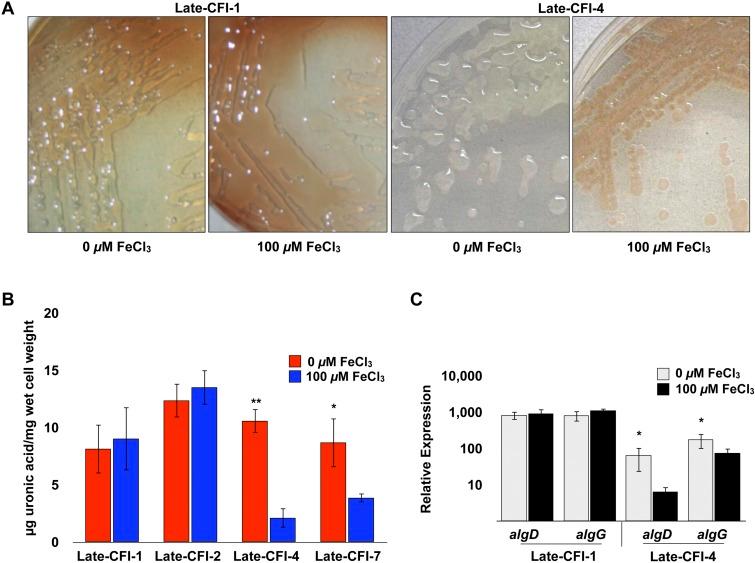
https://cdn.ncbi.nlm.nih.gov/pmc/blobs/d92f/3950519/3acb11184431/mbo0011417270004.jpg

铜绿假单胞菌藻酸盐产生、黏液样表型及生物膜形成的铁调节表达
Iron-regulated expression of alginate production, mucoid phenotype, and biofilm formation by Pseudomonas aeruginosa.
作者信息
Wiens Jacinta R, Vasil Adriana I, Schurr Michael J, Vasil Michael L
出版信息
mBio. 2014 Feb 4;5(1):e01010-13. doi: 10.1128/mBio.01010-13.
UNLABELLED
Pseudomonas aeruginosa strains of non-cystic fibrosis (non-CF) origin do not produce significant amounts of extracellular alginate and are nonmucoid. In CF, such isolates can become mucoid through mutation of one of the genes (mucA, mucB, mucC, or mucD) that produce regulatory factors that sequester AlgU, required for increased expression of alginate genes. Mutation of the muc genes in the nonmucoid PAO1, PA14, PAKS-1, and Ps388 strains led to increased levels of extracellular alginate and an obvious mucoid phenotype, but only under iron-limiting growth conditions (≤5 µM), not under iron-replete conditions (≥10 µM). In contrast, >50% of P. aeruginosa isolates from chronic CF pulmonary infections expressed increased levels of alginate and mucoidy both under iron-limiting and iron-replete conditions (i.e., iron-constitutive phenotype). No single iron regulatory factor (e.g., Fur, PvdS) was associated with this loss of iron-regulated alginate expression and mucoidy in these CF isolates. However, the loss of only pyoverdine production, or its uptake, abrogated the ability of P. aeruginosa to produce a robust biofilm that represents the Psl-type of biofilm. In contrast, we show that mutation of the pyoverdine and pyochelin biosynthesis genes and the pyoverdine receptor (FpvA) lead to iron-constitutive expression of the key alginate biosynthesis gene, algD, and an explicitly mucoid phenotype in both iron-limiting and iron-replete conditions. These data indicate that alginate production and mucoidy, in contrast to other types of biofilms produced by P. aeruginosa, are substantially enhanced under iron limitation. These results also have compelling implications in relation to the use of iron chelators in the treatment of P. aeruginosa CF infections.
IMPORTANCE
Pseudomonas aeruginosa is a leading model for the investigation of biofilms. While data have been generated about the role of iron in alginate-independent (Psl/Pel) biofilm development, there is a paucity of data regarding the role of iron in alginate production and its associated mucoid phenotype. We demonstrate that biologically relevant levels of iron that exist in the airway mucus of cystic fibrosis (CF) patients have a substantial influence on production of alginate and the overt mucoid phenotype, pathognomonic of P. aeruginosa infections in CF. Mucoid mutants of non-CF P. aeruginosa isolates are mucoid only under iron limitation and do not express increased levels of alginate under iron-replete growth conditions. However, a significant number of long-term CF isolates lost their iron-regulated expression of increased alginate production and mucoidy and became iron constitutive for these properties. In contrast to the formation of Psl-type biofilms, increasing iron limitation ultimately leads to an iron-constitutive expression of alginate and mucoidy.
未标记
非囊性纤维化(非CF)来源的铜绿假单胞菌菌株不会产生大量细胞外藻酸盐,且是非黏液型的。在CF患者中,此类分离株可通过产生调节因子以隔离AlgU(藻酸盐基因表达增加所必需)的基因(mucA、mucB、mucC或mucD)之一发生突变而变为黏液型。非黏液型PAO1、PA14、PAKS - 1和Ps388菌株中的muc基因突变导致细胞外藻酸盐水平升高和明显的黏液型表型,但仅在铁限制生长条件下(≤5μM)出现,在铁充足条件下(≥10μM)则不会。相比之下,超过50%从慢性CF肺部感染中分离出的铜绿假单胞菌菌株在铁限制和铁充足条件下(即铁组成型表型)均表现出藻酸盐水平升高和黏液化。在这些CF分离株中,没有单一的铁调节因子(如Fur、PvdS)与这种铁调节的藻酸盐表达丧失和黏液化相关。然而,仅绿脓菌素产生或其摄取的丧失就消除了铜绿假单胞菌产生代表Psl型生物膜的强大生物膜的能力。相比之下,我们表明绿脓菌素和绿脓杆菌素生物合成基因以及绿脓菌素受体(FpvA)的突变导致关键藻酸盐生物合成基因algD在铁限制和铁充足条件下均出现铁组成型表达以及明显的黏液型表型。这些数据表明,与铜绿假单胞菌产生的其他类型生物膜相比,藻酸盐产生和黏液化在铁限制条件下会显著增强。这些结果对于在治疗铜绿假单胞菌CF感染中使用铁螯合剂也具有重要意义。
重要性
铜绿假单胞菌是生物膜研究的主要模型。虽然已经有关于铁在不依赖藻酸盐的(Psl/Pel)生物膜形成中的作用的数据,但关于铁在藻酸盐产生及其相关黏液型表型中的作用的数据却很少。我们证明,囊性纤维化(CF)患者气道黏液中存在的与生物学相关水平的铁对藻酸盐的产生和明显的黏液型表型有重大影响,这是CF中铜绿假单胞菌感染的特征性表现。非CF铜绿假单胞菌分离株的黏液型突变体仅在铁限制条件下是黏液型的,在铁充足的生长条件下不会表达升高的藻酸盐水平。然而,大量长期CF分离株失去了其铁调节的藻酸盐产生增加和黏液化表达,并在这些特性上变为铁组成型。与Psl型生物膜的形成相反,铁限制增加最终导致藻酸盐和黏液化的铁组成型表达。